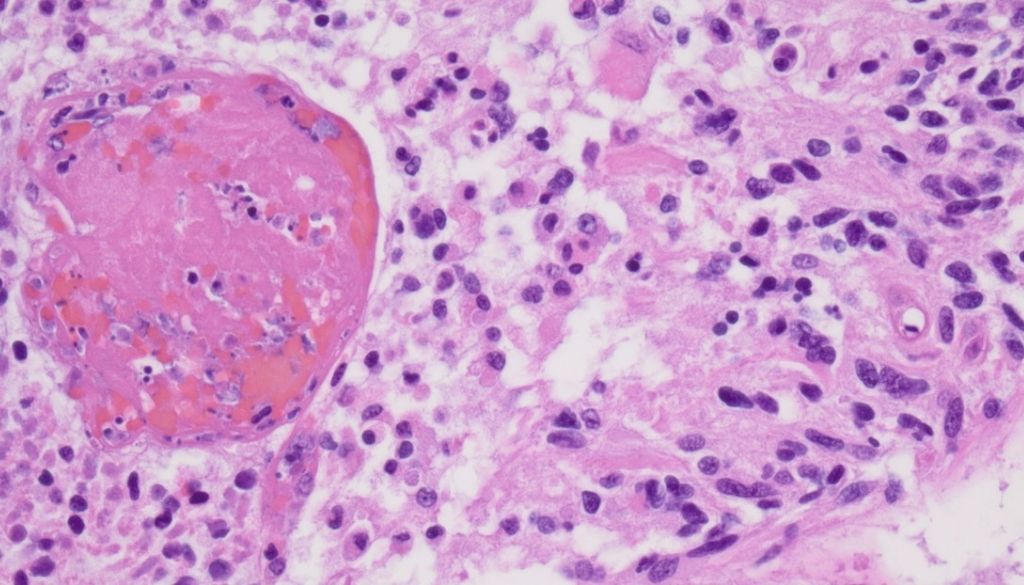

Informática Biomédica: 5 cursos que pueden ayudarte a conocer mejor una de las especialidades del futuro.

Autor: Redacción DiarioSalud Estudiantil. La Informática Biomédica es un campo interdisciplinario relativamente nuevo en la industria de la salud que utiliza la tecnología de la información para organizar y analizar registros de salud para mejorar los resultados de la atención médica. Esta área es la intersección entre el trabajo de las partes interesadas en la […]
Google lanza aplicación de asistencia dermatológica

SANTO DOMINGO.- Google desarrolló una nueva aplicación médica para la piel fuera de EE. UU, la cual funciona con inteligencia artificial y permite que las personas detecten afecciones de la piel mediante de la cámara de su teléfonos móviles. Para ello el individuo debe tomar tres fotos de su defecto desde diferentes ángulos y distancias […]
Un nuevo método utiliza nanotecnología para mejorar los fármacos contra el cáncer

Los genes que han mutado y contribuyen al desarrollo de un cáncer son denominados oncogenes. Uno de los más relevantes en procesos tumorales es el gen p53, ya que se estima que más del 70 por ciento de los tumores sólidos y hematológicos presentan mutaciones puntuales de este oncogén. Por esta razón, un estudio internacional […]
Investigadores desarrollan un biochip que permite fabricación de piel in vitro

ESPAÑA.-Investigadores de la Universidad Politécnica de Madrid y de la Universidad Carlos III de Madrid, en conjunto con otras entidades han desarrollado un biochip que permite el cultivo de piel in vitro. El dispositivo está dividido en dos canales superpuestos separados por una membrana porosa, por el canal inferior se simula el flujo sanguíneo y […]
GooApps participa como partner en el Barcelona Health Hub Summit

BARCELONA.-GooApps, en la persona de su CEO, Eric García, participó como Summit que realizó recientemente la asociación Barcelona Health Hub, con el objetivo de promover la innovación en el sector salud. GooApps también apuesta por la innovación en el sector salud materializándolo en su línea de negocio GooMedical, que aporta soluciones digitales específicas para el […]
Nextium presenta sistema para diagnóstico de enfermedades con inteligencia artificial

BARCELONA.-Con el propósito de apoyar a los profesionales de la salud hispanohablantes, la empresa Nextium, de Indeo, desarrolla y fabrica tecnología contactless de monitoreo de constantes vitales. La misión de Nextium es ayudar al desarrollo de un sistema médico más sostenible a partir del aumento del uso del diagnóstico y el seguimiento de pacientes con […]
Nubentos, la startup que acelera la adopción de la salud digital

BARCELONA.- Nubentos llega al ecosistema de la salud para ocupar un rol que según sus fundadores, era necesario cubrir para acelerar la digitalización de la Salud. Su plataforma mediadora en la nube, permite simplificar de forma significativa el proceso de descubrimiento, acceso e integración de cualquier innovación en salud digital, en cualquier software para la […]
COCO Tecnologías, la solución que revoluciona la forma en cómo las clínicas interactúan con sus pacientes

BARCELONA. -Con el objetivo de dignificar el acceso a la salud para todos, la empresa COCO Tecnologías, presenta sus servicios a la comunidad hispanoamericana. Esta empresa Colombiana transforma las clínicas tradicionales en clínicas digitales, mejorando la experiencia tanto de pacientes como de profesionales con un software de soluciones integradas que aumentan la capacidad de atención […]
AB Health Solutions, servicio de consultoría que garantiza innovación en tecnología salud se traduzca en soluciones duraderas

BARCELONA.- Con el objetivo de cerrar la brecha entre médicos y desarrolladores en salud digital, la empresa AB Health Solutions, expertos en consultoría, presenta sus servicios a la comunidad hispanoamericana. AB Health Solutions es un servicio de consultoría único que proporciona experiencia médica internacional para garantizar que la innovación en tecnología de la salud se […]
Entidades se unen a favor de la innovación en salud digital

BARCELONA.- La startup Legit Health, de la mano de Biome Novartis, ha demostrado la importancia que tiene el avance de la innovación y la tecnología en el ámbito sanitario a la hora de salvar vidas, al participar en el Barcelona Health Hub Summit. La aplicación Legit.Health permite una detección temprana de hasta 232 patologías […]
Lanzan plataforma para fomentar fabricación productos de salud en las Américas

SANTO DOMINGO.- La Organización Panamericana de la Salud (OPS) lanzó formalmente la Plataforma Regional para el Avance en la Producción de Vacunas y otras Tecnologías Sanitarias para la COVID-19 en las Américas. Durante el acto de presentación Jarbas Barbosa da Silva Jr, Subdirector, OPS, detalló que dentro de los aspectos positivos de la plataforma está […]
Impulsarán producción de vacunas y tecnologías sanitarias en la región

SANTO DOMINGO.-La Organización Panamericana de la Salud (OPS) lanzará este viernes la Plataforma Regional para el Avance en la Producción de Vacunas y otras Tecnologías Sanitarias para la COVID-19 en las Américas. Según explicó la entidad en el anuncio del evento, el lanzamiento contará con un foro entre los Estados Miembros, organismo de Naciones Unidas […]
Científicos imprimen en 3D el primer tumor cerebral maligno activo del mundo
Un equipo de científicos israelíes ha conseguido imprimir con éxito el primer tumor cerebral maligno activo del mundo utilizando una impresora 3D, siendo hasta el momento el modelo más complejo desarrollado en laboratorio, detalla un estudio publicado esta semana en la revista Science Advances. Investigadores de la Universidad de Tel Aviv imprimieron un glioblastoma en […]
Diseñan prótesis de mano que mejora con el tiempo

SANTO DOMINGO.-La empresa Esper Bionics presentó su producto “Sper Hand”, la primera mano biónica que mejora y gana habilidades a través del tiempo de uso. Según destacó la empresa en su sitio web, esta prótesis utiliza sensores mioeléctricos que permiten que las señales generadas por los músculos de la persona muevan la prótesis, a través […]
Crean microrobots capaces de moverse en el sistema nervioso central

Un equipo de investigadores trabaja en el diseño de microrobots blandos de manipulación remota que pueden ser útiles para la administración dirigida de fármacos en regiones específicas de tejidos sensibles. De acuerdo al artículo “Soft Capsule Magnetic Millirobots for Region-Specific Drug Delivery in the Central Nervous System”, publicado en la revista Frontiers in Robotics and AI, […]
Crean dispositivo personalizado para tratar apnea del sueño

SANTO DOMINGO.-OrthoApnea lanzó su Dispositivo de Avance Mandibular OrthoApnea NOA, para tratar la apnea del sueño, que se adapta a la biomecánica mandibular del paciente, lo que aumenta la eficacia y comodidad. De acuerdo con la empresa, este dispositivo desarrollado en un entorno digital se adapta al movimiento de la mandíbula y evita problemas de […]
